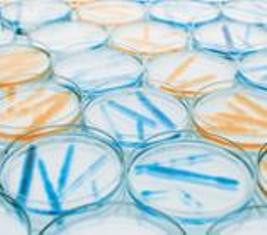

PUR-010
This procedure describes the steps to be followed by planning and procurement department to create purchase order for inventory items to be purchased from overseas and local suppliers.
PUR-010 Generation of Purchase Order For Inventory and Consumables